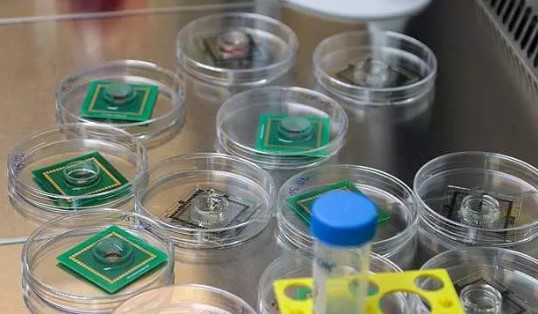
Foto - Rüya değil gerçek! İnsan beyninden bilgisayar ürettiler!
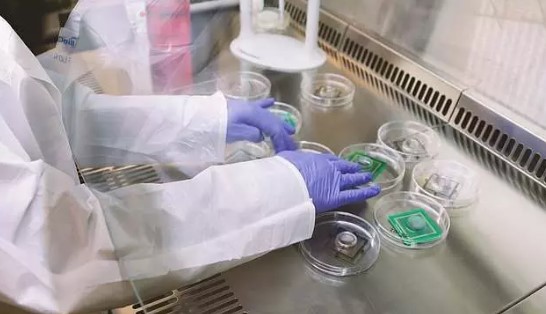
Foto - Rüya değil gerçek! İnsan beyninden bilgisayar ürettiler!
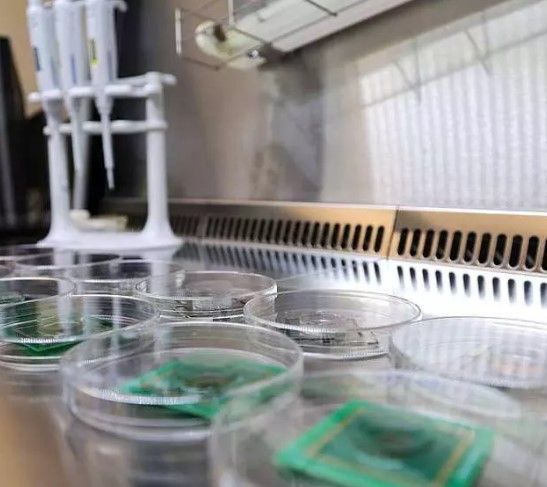
Foto - Rüya değil gerçek! İnsan beyninden bilgisayar ürettiler!

Rüya değil gerçek! İnsan beyninden bilgisayar ürettiler!
Bilim adamları, dünyanın ilk insan beyinden yapılan bilgisayarını üretti. Bu teknolojinin bilgisayar dünyanın enerji krizini çözebileceği düşünülüyor. işte bilim kurgunun gerçeğe dönüştürüldüğü o bilgisayar.